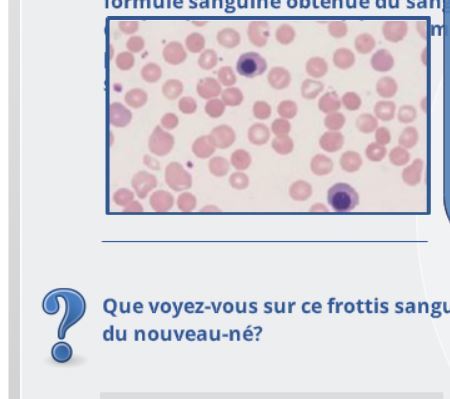

Est elle anémique?




C’est quoi la formule pour calculer le vgm?
Hématocrite X 1000
/
nb GR

V/f Les valeurs d’hémoglobines normales chez l’enfant sont plus élevé et chez la femme enceinte plus basse
NOP!!!
Chez le NOUVEAU NÉ —) PLUS ÉLEVÉ
Mais chez enfant et femme enceinte –) PLUS BASSES

Donne moi 5 symptomes COMPENSATOIRES d’anémie
- ACOUPHÈNE
- CÉPHALÉE PULSATILE
- TACHYCARDIE, palpitations
- Orthopnée ( décompensation gauche)
- Oedeme malléolaire ( décompensation droite)

La cellule souche _____ est à l’origine des 3 lignées cellulaires ___ ___ ___
MYÉLOIDE
- Granulocyte
- plaquette
- Érythrocyte

Est-il anémique?








donne les deux méthodes possibles pour faire la première correction
Soit avec globule rouge ou hémoglobine
multiplie par la valeur du malade la réticulocytose du malade
pis then divise par la valeur normale
voila







v/f Une prolifération Augmenté peut quand meme etre associé à une anémie arégénérative
OUI
Si défaut de MATURATIOn
bah PROLIÉRATION aera augmenté mais…

Honnetement c’est hard à voir

?

ALPHA!!!
est à 18 % après première correction est à cmb?
Après ta première correction quelle autre info tu va vouloir savoir?
on est chez un nouveau né

pretty simple actually , mais faut le savoir
Comme après première correction on est en haut de 2 % ,
Faut faire deuxième correction
Pour savoir comment la faire
FAUT SAVOIR SI Y’A DE LA POLYCHROMATOPHILIE

v/f
un homme à 120 d’HB peut avoir aucune patho et que ca soit son hémoglobine normal
yeah of course
cpk deux écarts type

l’électrophorèse de l’hB sur acétate de cellulose est un test couramment utilisé en hémato pour le Dx des ______
HÉMOGLOBINOPATHIE CONGÉNITALES

T’as une personne anémie normochrome normocytaire
avec rétioculocytose 3,5 %
Regénératif ou arégénératif?
Tu peux pas dire tant que t’as pas ton index ???
Pk y’en parle pas dans les notes?




































































